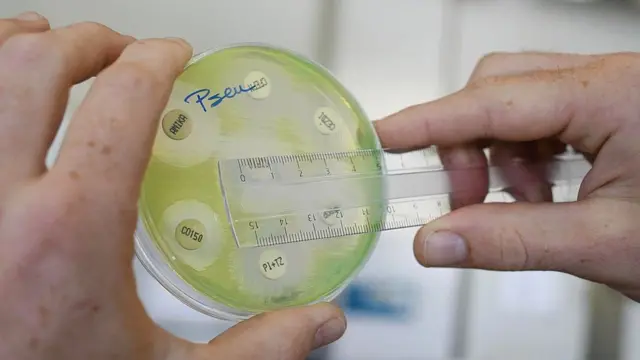
کشت باکتری

آنتیبیوتیک 'جادویی 'برای مبارزه با میکروبهای مقاوم ساخته شده است

منبع تصویر، Getty Images
پژوهشگران از کشف داروی جدیدی برای مبارزه با باکتریهای مقاوم در برابر آنتیبیوتیکها خبر دادهاند.
موسسه تحقیقاتی اسکریپس Scripps در آمریکا گفته است که پژوهشگران این موسسه با تغییراتی در آنتیبیوتیک وانکومایسین Vancomycin داروی جدید ساختهاند که از سه راه مختلف بر باکتریها اثر میکند و به این ترتیب، مانع از مقاومت آنها در برابر آنتیبیوتیک شود.
وانکومایسین حدود شصت سال است که برای بیماری های عفونی تجویز شده اما به تازگی باکتریها نسبت به نوع متعارف آن مقاومت نشان دادهاند.
موسسه اسکریپس گفته است که پزشکان میتوانند نوع جدید این دارو را بدون نگرانی از مقاوم شدن باکتریها در برابر آن به کار گیرند.
سازمان بهداشت جهانی باکتریهای مقاوم نسبت به آنتیبیوتیک را بزرگترین تهدید نسبت به سلامت، امنیت غذایی و توسعه اقتصادی و اجتماعی در سطح جهانی توصیف کرده و گفته است که با مقاوم شدن میکروبها نسبت به آنتیبیوتیکهای موجود، درمان بسیاری از بیماری ها با این داروها دشوار و حتی ناممکن خواهد شد و جهانیان را با وضعیتی مواجه خواهد کرد که از زمان کشف آنتی بیوتیکها دیده نشده است.
منبع تصویر، Getty Images
به گفته کارشناسان، استفاده مکرر و بیش از اندازه از آنتیبیوتیکها باعث جهش ژنتیکی و ظهور باکتریهایی میشود که این داروها بر آنها تاثیری ندارد. به عبارت دیگر، بشر به تدریج در برابر این باکتریها خلع سلاح میشود.
دقت در استفاده از آنتیبیوتیکها یکی از راههای جلوگیری یا در واقع، کُند کردن روند ظهور باکتریهای مقاوم است اما در نهایت، پزشکان امیدوار بودهاند که داروهایی کشف شود که باکتریها قادر نباشند در برابر آن مقاوم شوند.
به گفته پژوهشگران موسسه اسکریپس، مدت زمان مقاوم شدن باکتریها نسبت به وانکومایسین نشان داد که این روند به سادگی صورت نمیگیرد. وانکومایسین به خاطر تاثیری که در نابودی باکتریها داشته به "داروی جادویی" شهرت یافته و تحقیقات قبلی نیز نشان داده بود که میتوان با تغییراتی در ساخت آن، بر کارآیی این دارو افزود.
نتیجه تحقیقات جدید که در نشریه گزارشهای آکادمی ملی علوم منتشر شده حاکی از تغییر دیگری در این دارو است به نحوی که میتواند به شکلی جدید بر باکتریها اثر بگذارد. به گفته پژوهشگران، در مجموع، تغییراتی که در وانکومایسین داده شده کارآیی آن را هزار برابر بیشتر و ادامه استفاده از این دارو را برای مدتی طولانیتر امکانپذیر کرده است.

#ازمابپرس
از شما خواسته بودیم که اگر میخواهید مطالب بیشتری درباره آنتیبیوتیکها و مصرف آنها در بیبیسی فارسی بخوانید، سوالهای خود را برای ما بفرستید.
فرصت فرستادن سوال برای این موضوع به پایان رسیده است.
ممنون از شما که سوال فرستادید. مطلب زیر در پاسخ به این سوالها تهیه شده است:
#ازمابپرس ابزاری است که به شما امکان میدهد تا با سوالهای خود در تهیه مطالب و گزارشهای بیبیسی فارسی سهیم شوید.






























